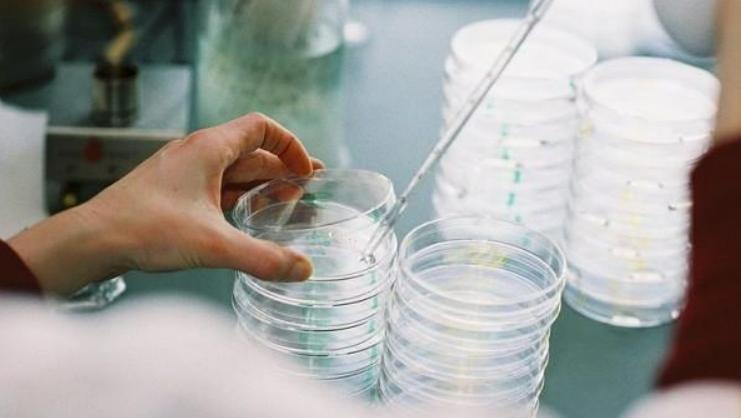
科学家复活潘多拉病毒 (人们为什么要复活潘多拉病毒)

11月23日,英国《新科学家》杂志报道:来自法国的科学团队复活了西伯利亚永久冻土中的病毒,其中最古老的病毒来自于48500年前。这份被复活的病毒仍具有感染性,属于pandoravirus type(潘多拉病毒)。潘多拉的魔盒已被打开,人类是否会面临灭顶之灾?

在该篇报道中,我们可以知晓,研究团队一共复活了七种病毒。距离我们最近的都已经有27000年了。而最古老的48500年时迄今为止发现并复活的最古老病毒,这次实验无疑刷新了人类的记录。
其实,该团队此前就已经复活过两种三万年前的病毒,这种操作算是轻车熟路了。本次研究的样本取自西伯利亚一处湖面之下十六米深处的永久冻土。

在本次实验中,研究者们将冻土样本添加到变形虫的培养皿中,在经过长时间观察后,研究者们赫然发现那些尘封多年的病毒们竟然复活了!它们不但自我复活,还能进行自我复制。复活的是一种巨型病毒,属于潘多拉病毒,主要针对感染单细胞变形虫。潘多拉源自希腊神话,以此命名的病毒有何奇特之处呢?
潘多拉魔盒
在希腊神话中,潘多拉是被众神创造的第一位女性人类,每位神灵赠与她一件礼物:爱神阿佛洛狄忒(维纳斯)赠予她妩媚,智慧女神雅典娜为她打扮,汉密斯给她取名“潘多拉”,意为“所有的礼物”,宙斯给了她一个密封的盒子。当美丽的潘多拉下嫁人间,她在好奇心地驱使下打开了盒子,里面竟然飞出了灾难、瘟疫等灾祸。从此人类饱受各种灾害的困扰。此为“潘多拉魔盒”的由来。

时间来到了2013年,一支研究团队分别于智利中海岸和澳大利亚墨尔本附近的淡水池中发现了两种奇特的生物。最初研究团队把它们当作细菌来研究,因为它们的体型对于病毒来讲太大了,更像是细菌的体量。可随着研究的深入,研究者们发现这其实不是细菌,而是巨型病毒!
这一突破性的发现打破了传统上“病毒比细菌小很多”的认知,打开了人们全新的视野,如同打开潘多拉魔盒一般。为此,研究团队给它们起名“潘多拉病毒Pandoravirus”。他们相信,这已经打开了病毒世界的大门!

在此之后,世界上的科学家门陆续发现不少巨型的潘多拉病毒,最大的潘多拉病毒是“西伯利亚阔口罐病毒”,直径超过0.5微米,大到用光学显微镜就可以看到。
在最新的潘多拉病毒研究实验中,科学家们已经证实了距今四万多年前的病毒在适宜的条件下都有可能复活,并感染活细胞。
某些网友可能已经在担心了,这帮作妖的科学家们怎么闲着没事要去复活陈年古老病毒呢?难道是打算灭绝人类吗?
其实这点大可不必担心,毕竟这些实验都是在严格规范的实验室内完成,严禁外溢,不会对社会造成什么影响。请让我们相信科学家们的基本素养。
但是这次实验给了我们另一个警醒:冻土层中更多的病毒都有可能复活并造成危害。研究团队担心这些危险性尚无法确定的远古病毒会随着冻土层的消融,不断出现在人类社会当中。

早在2016年,北极圈内的马尔半岛冻土层就由于当年异常炎热的天气而逐步融化,其间释放出了冰封已久的炭疽病毒。该此泄露事件导致二十多人入院,一名孩子身亡,最终,当地居民被迫全部撤离。

早前俄国就已发出警告,由于气候变化导致的永久冻土层融化已经在危险边缘,甚至早在2021年,俄罗斯代表尼古拉·科尔楚诺夫就曾坦言,这些即将融化的冻土中可能含有病毒、细菌、或孢子。
在某些地方,人们甚至可以通过肉眼直接看到冻土层的大量裸露,其中一些史前动物的遗骸纷纷被发现。我们不知道当初它们是如何死亡,如何被冰封的。我们也无法预知这些远古生物身上是否存在着我们未知的远古病毒。

一场席卷全球的疫情已经让你我深刻感受到了这些看不见、摸不着的小东西是多么的可怕。如果众多古早病毒释放出来,对于人类来讲绝对又是一大考验!
那么,导致这一切发生的是什么呢?
全球暖化!
其实答案你我都很清楚,由于人类频繁的活动加剧了温室效应,导致全球平均温度升高,南北极的巨型冰川在融化,西伯利亚冻土在解封,喜马拉雅冰川在消失,种种迹象都在揭示:全球暖化的步伐越来越快了!

温度距平
目前全球平均温度是15℃左右,每年的温度如果超过平均温度1℃,我们就称之为“温度距平”+1℃,如果连年温度距平都是正值,说明这些年温度都在上升。
今年公布的最新数据显示:我们赖以生存的地球一个世纪以来的温度距平都是正值,而且最近几年冲上了1℃。按照这个趋势发展下去,五年之内就会突破1.5℃的临界值,超过《巴黎协议》预估的标准。

即便没有科学数据,单凭我们的感受,你我都能明显地感受到今年夏天的异常高温。鄱阳湖、洞庭湖大面积干涸。我国各地出现极端高温,23个省份录得40℃以上的记录,366个国家气象站创造了历史最高温记录!超过500万平方公里的地域受到高温影响,部分地区高温时间持续79天!
非洲河流干涸、美洲被热浪侵袭、欧洲超过1.5万人因高温死亡,全球都在忍受高温的洗礼!联合国政府间气候变化专门委员会(IPCC)给全球设定了15个“气候临界点”,一旦温度超过临界点,就会出现重大变化。但到今年已经有9个气候临界点失守。

IPCC曾做出警告:当气候突破临界点,生态平衡将会被打破,动植物生存出现重大危机,生物多样性受到严重挑战。地球上的水资源、各类能源将会产生重大且深远的变化。
面对如此严峻的形势,难道我们人类还能坐以待毙吗?
当然不能!我们要为人类的生存而战!
《气候变化框架公约》、《京都议定书》,《巴黎协定》是全球联合起来做出的努力;“碳达峰”、“碳中和”是我国为此制定的目标;就你我个人而言,健康出行、节能环保、减少排放都是力所能及的行动。如果条件允许,更是可以投身到清洁能源建设上来。

西伯利亚的冻土层融化已经为我们敲响了生存的警钟,48500年前的古老病毒警醒着我们生存危机的到来,潘多拉的魔盒已开启,唯有你我都行动起来,才有可能赢得生存之战的胜利!
作者:方骥 校稿:川川